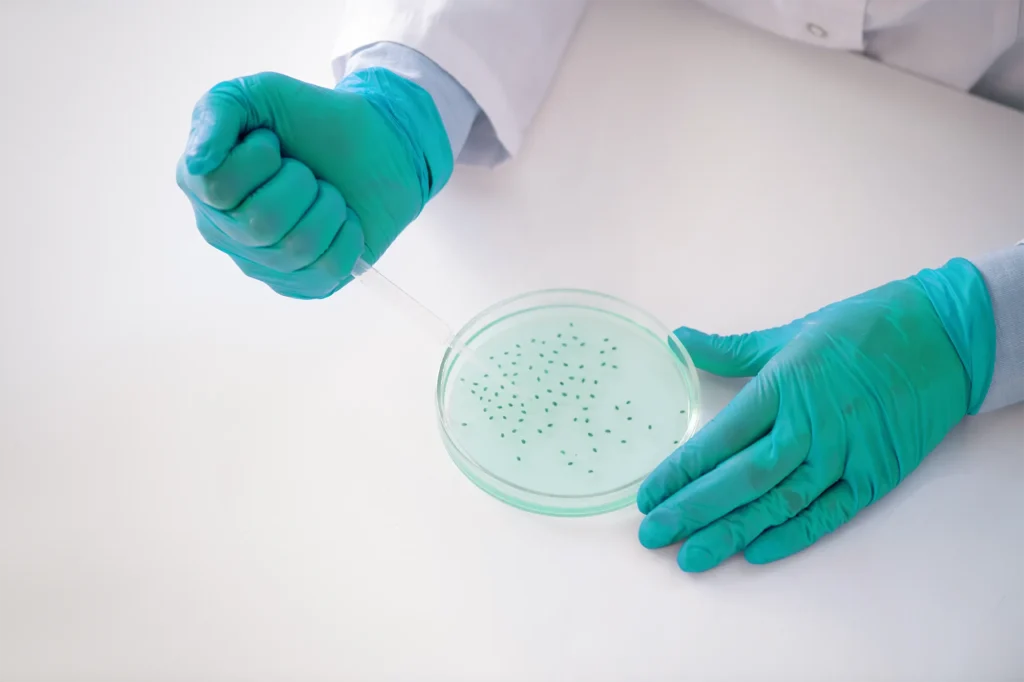

Why Longevity & Regenerative Medicine?
Healthcare and aesthetic medicine are shifting from symptom treatment to cellular repair, prevention, and longevity-focused care.
This training is designed for professionals who want to stay clinically relevant, scientifically updated, and aligned with the future of medicine and aesthetics.
If longevity medicine isn’t part of your practice yet, it should be.
Program Overview

The Longevity & Regenerative Medicine Training is a 2-day intensive program combining:
- Evidence-based theoretical education
- Practical, clinical-oriented applications
- A clear focus on safety, protocols, and real-world use
This course bridges medical science and aesthetic practice, giving participants practical tools they can integrate immediately.
What You Will Learn
Core Topics Covered
Peptides
- Mechanisms of action
- Clinical indications
- Safe application protocols
Stem Cells IV Therapy
- Clinical overview and use cases
- Safety considerations
- Patient selection principles
Exosomes in Clinical Practice
- Role in cellular repair and regeneration
- Aesthetic and medical applications
- Evidence-based insights
Peptide-Based Skin Applications
- Skin rejuvenation and repair
- Integrating peptides into aesthetic protocols
Teaching Format
✔ Structured academic sessions
✔ Clinical-focused explanations
✔ Practical demonstrations
✔ Small-group learning
✔ Emphasis on safety, ethics, and evidence
This is not theory-only. The training is designed to support confident, responsible application.
Accreditation
IAO Accredited Training
This program is accredited by the International Accreditation Organization (IAO), confirming that:
- The curriculum meets international quality standards
- The training follows structured academic systems
- The certificate is internationally recognized
Accreditation adds credibility, supports professional growth, and strengthens your profile in regulated markets like the UAE.

Who Should Attend?
This training is open to:
- Doctors
- Physicians
- Nurses
- Beauty Therapists
- Healthcare Professionals
Eligibility is subject to professional background and regulatory requirements.
Why Choose Yugen Care Academy?
- Internationally accredited education
- Science-driven curriculum
- Hands-on, practical focus
- Industry-relevant topics
- Training aligned with modern clinical and aesthetic standards
ACCREDITATIONS
DHA – Dubai Health Authority / KHDA – Knowledge and Human Development Authority / NCLC – National Council of Laser Certification / AACME – American Association of Continuing Medical Education / CIDESCO – Comité International d’Esthétique et de Cosmétologie / IAO – International Accreditation Organization






